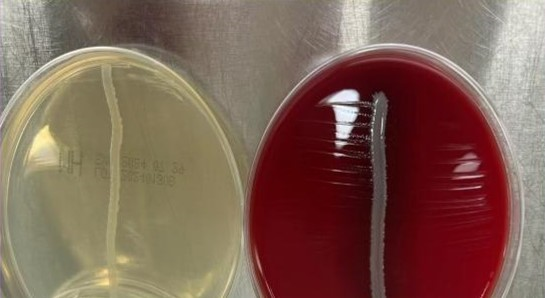
图片1.jpg 图片1.jpg

嗜血杆菌属大多为上呼吸道正常菌群,为革兰阴性球杆菌,无芽胞,无鞭毛,多数菌株有菌毛,有毒株有荚膜,陈旧培养基中荚膜易消失。需氧或兼性厌氧,5%~10%CO2,可促其生长。营养要求高,有些菌株因氧化还原系统不完善,需要Ⅹ因子(正铁血红素)和Ⅴ因子(烟酰胺腺嘌呤二核苷酸),故一般使用巧克力平板分离培养。菌落小而透明,有荚膜的流感嗜血杆菌形成光滑型菌落。
概念:当将金黄色葡萄球菌与流感嗜血杆菌在同一血琼脂平板上共同培养时,由于前者能合成较多的X、V因子,促进后者生长,故在金黄色葡萄球菌菌落周围生长的流感嗜血杆菌菌落较大,距离越远的菌落越小,此现象称为“卫星现象”(satellite phenomenon)
目的:鉴别流感嗜血杆菌和副流感嗜血杆菌病毒。
方法:挑取可疑菌落密涂于血平板和MH平板上,再将金黄色葡萄球菌划线其上,35°C孵育24小时,金黄色葡萄球菌产生溶血素裂解血平板中的红细胞,释放V因子和X因子。同时金葡菌分泌V因子。
结果:靠近金黄色葡萄球菌的嗜血杆菌菌落较大,远离金黄色葡萄球菌的嗜血杆菌菌落较小,即卫星现象阳性。
意义:副流感嗜血杆菌只需要v因子就可以生长,在MH平板上可以呈现卫星现象;流感嗜血杆菌同时需要V因子和X因子,在血平板上呈现卫星现象。